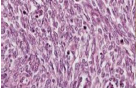

DSS: Redefining Biotechnology & Life Science in India
- About Us
- Products & Services
PRODUCTS & SERVICES
- Applications & Specialities
All Applications & Specialities
- Brands
- Contact Us
-
-
0
- ☰
×
- About Us
- Products & Services
-
Kits Reagents & Consumables
- Cytogenetics
- Dyes
- Fluorescence In Situ Hybridization (FISH)
- High-Performance Liquid Chromatography (HPLC)
- Histology
- Immuno Histo Chemistry (IHC)
- IVF Consumables
- Molecular Pathology & Diagnostics
- Multiplex Ligation-Dependent Probe Amplification (MLPA)
- Nucleic Acid Extraction
- PharmDx
- Real Time PCR
- Special Stains
- Instruments
- Software
- Accessories
- Advanced Material
- Therapies
-
Kits Reagents & Consumables
- Applications & Specialities
- Brands
- Brand - Life Sciences
- 3i
- ABBERIOR INSTRUMENTS
- Abbott Molecular
- ADS Biotec
- APPLIED SPECTRAL IMAGING
- BioAir Tecnilabo
- DAKO (AGILENT)
- Eden Tech
- Elveflow
- ENTROGEN
- EUROCLONE
- EVIDENT
- Genea
- Hamamatsu Photonics
- Invivoscribe
- MASTER DIAGNOSTICA
- MBF BIOSCIENCE
- Medical Tek Co. Ltd
- MILESTONE MED SRL
- Molecular Machines & Industries
- MRC HOLLAND
- NeoDx
- Onward Assist
- Profound
- SCIENTIFICA
- SpaceGen
- Seqlo
- µCyte
- Brand - Industrial
- Brand - Life Sciences
- News & Events
- Career
- Contact Us
- Testimonial
- Blogs
- R&D
- CSR
- Press Release